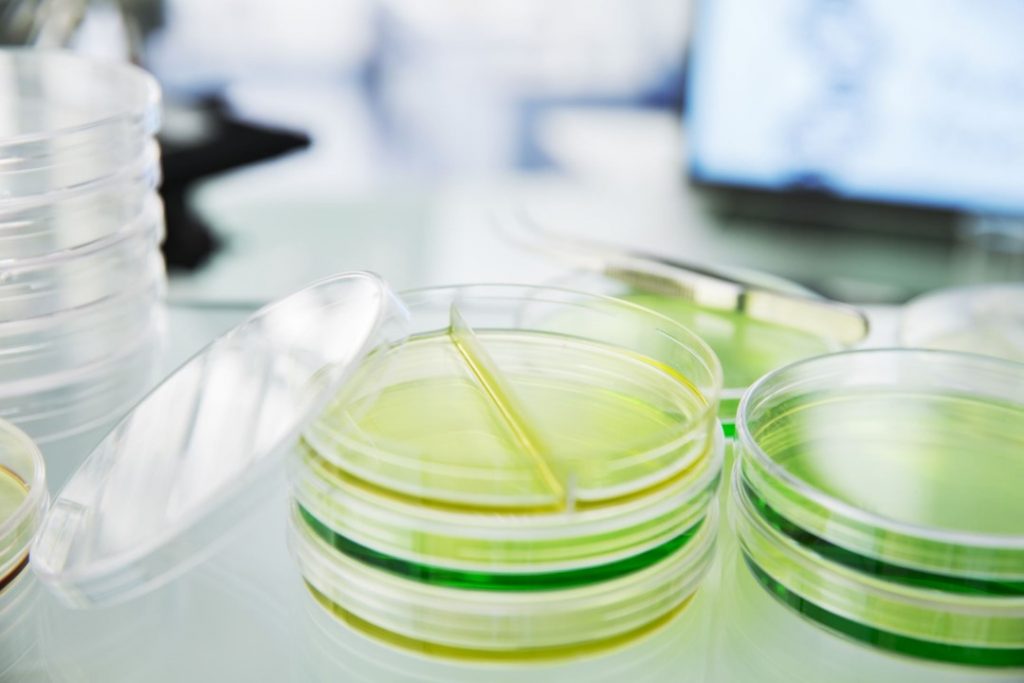

Synthetic antibody: Prospects in aquaculture biosecurity
The emerging technology of aptamers that is also known as synthetic antibodies is rivalling antibodies research in the recent years. The unique yet important features of aptamers are advancing antibodies in diverse applications, which include disease diagnosis, prophylactic and therapeutic. The versatility of aptamer has further extended its application to function as gene expression modulator, known as synthetic riboswitches. This report reviewed and discussed the applications of aptamers technology in the biosecurity of aquaculture, the promising developments in biosensor detection for disease diagnosis as well as prophylactic and therapeutic measurements. The application of aptamers technology in immunophenotyping study of aquatic animal is highlighted. Lastly, the future perspective of aptamers in the management of aquatic animal health is discussed, special emphasis on the potential application of aptamers as synthetic riboswitches to enhance host immunity, as well as the growth performance.

Peculiarities of innate immune memory in crustaceans
Classical characteristic of the innate immune system is the lack of ability to build up immunological memory, contrast to the adaptive immune system that is capable of “remembering” antigens, and rapidly mount a greater magnitude of immune response upon subsequent exposure to the same antigens. Peculiarly, immunological memory of innate immunity is evidenced in invertebrates. At least three different memory phenomena have been described, namely sustained unique response, recalled response, and immune shift. Studies attended to decipher the mechanistic biology of the innate immune memory reveals the role of epigenetics, which modulates the response of immune memory, and the heritability of immune memory to subsequent generations. A parthenogenetic Artemia model demonstrated successful transgenerational epigenetic inheritance of resistance trait against Vibrio campbellii. Following, the role of invertebrate hemocytes and Down syndrome cell adhesion molecule (Dscam) in innate immune memory is reviewed. While there is no vertebrate antibody homolog found in invertebrates, Dscam was found to resemble the functionality of vertebrate antibody. Insight of Dscam as immune factor was illustrated further in the current review.

Feasibility of vaccination against Macrobrachium rosenbergii nodavirus infection in giant freshwater prawn
The giant freshwater prawn/giant river prawn, Macrobrachium rosenbergii is one of the high market value crustaceans cultured worldwide. The intensified aquaculture of the species has led to the outbreak of infectious diseases, prominently, the white tail disease (WTD). It is caused by the infection of Macrobrachium rosenbergii nodavirus (MrNV), which was classified in the family of Nodaviridae. To-date, there are no effective prophylactic and therapeutic agents available against MrNV infection. Vaccination is known to be the most effective prophylactic agent in disease prevention. However, vaccine development against virus infection in crustaceans is equivocal. The feasibility of vaccination in conferring immune protection in crustaceans against infectious diseases is disputable. The argument lies in the fact that crustaceans do not possess adaptive immunity, which is the main immune component that functions to establish immunological memory upon vaccination. Nevertheless, an increasing number of literatures has been documented, which concerns the development of vaccines against infectious diseases in crustaceans. The current review deliberates different approaches in vaccine development against MrNV, which were documented in the past years. It is noteworthy that the live-attenuated MrNV vaccine has not been experimented by far. Thus, the potential of live-attenuated MrNV vaccine in conferring long-term immune protection through the establishment of innate immune memory is currently being discussed.
Middle Eastern Plant Extracts: An Alternative to Modern Medicine Problems
Middle Eastern countries are primarily known for their dry sand deserts; however, they have a wider physiographic range which includes upland plateau and mountain ranges. The Middle East is home to various types of plants, such as Phoenix dactylifera (date palm tree), Scrophularia striata (herbaceous plants), and Opuntia ficus-indica (cactus). These plants have been found to have various types of bioactivities, such as antimicrobial activities against both bacteria and fungi, in addition to exhibiting anti-inflammatory effects and anti-cancer characteristics which can be utilized in the clinical setting for treatment. Due to limited reviews focusing on plant extracts from the Middle East, we aim to provide a discourse on plants from this region which have various bioactivities and to provide information on the compounds that can be identified from these plants. This is to enhance our understanding to improve modern medicine problems such as antimicrobial resistance and to find an alternative cure for cancer. It is hoped that the collation of information from this review will enable an assessment of the direct role of Middle Eastern plants in providing therapeutic options to address the predicaments in the medical field.